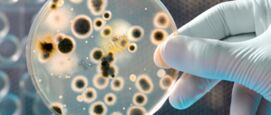
Superbacteriën multiresistent, zorgwekkende toename

Bacterie in drinkwater Boxtel (E. colibacterie): drink het niet!

Bacterie in drinkwater Boxtel (E. colibacterie): drink het niet!

Noodlanding TUI-vlucht veroorzaakt paniek aan boord

Recessie-alarm: niet de vraag óf, maar wanneer het toeslaat

Anne Frank beeld met rode verf beklad op symbolische dag
Superbacteriën die multiresistent zijn: gezondheidszorg vreest

Komt de zelfrijdende auto die ons is beloofd er nu wel of niet?

Veel royals voelen zich nauw verbonden met de Olympische Spelen

Vuilnismannen leven dagelijks in angst en vrezen zelfs voor hun leven

Efficiëntie in ziekenhuizen: lange wachtlijsten eindelijk voorbij?

De beste sekstips en seksspeeltjes voor een ontspannen vakantie

Youp van ’t Hek leeft 2 weken in Italiaanse hel

Je lichaam heeft vitamines en mineralen nodig maar pas op voor overschot

Checklist voor je autovakantie om volop te genieten van je vrijheid

Top 10 beste landen om te leven als je met pensioen gaat

Aantal verdrinkingen in Nederland fors gestegen, vooral onder 60-plussers

Het dark web, zo beland je in de krochten van het internet

AI-modeshow Elon Musk maakt van wereldleiders karikaturen

Zomerse coronavariant FLiRT zorgt voor nieuwe besmettingsgolf

Paniek en spijt bij caravanbezitters: groot tekort aan stallingsplekken

Olympische Spelen: modemerken gaan voor goud

Moordaanslagen op presidenten, Amerika lijkt er een abonnement op te hebben

Koning Charles leeft mee met Donald Trump en schrijft hem een brief

Spanje wint EK voetbal 2024: bekijk hier de uitslagen

Vakantie: 1 op de 5 heeft geen zin, geen geld of gezondheidsklachten